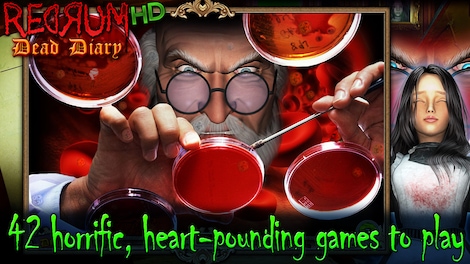
Redrum: Dead Diary Steam Key GLOBAL - 9

Rose sees dead people who have been killed unjustly, with their mortal wishes left unfulfilled. Her super-practical father refuses to believe her ghostly visions and puts her in an asylum, where she falls into the clutches of the evil Dr. Sigmund Fraud. Help Rose use her psychic powers to solve gruesome murders and outwit a homicidal maniac in this spine-chilling mystery.
Key features:
- Horrific, heart-pounding games to play
- Solve grisly murders across seven chapters
- Impressive graphics and haunting music
- Use psychic powers to outwit a homicidal maniac
- Help Rose escape the clutches of the evil Dr. Fraud